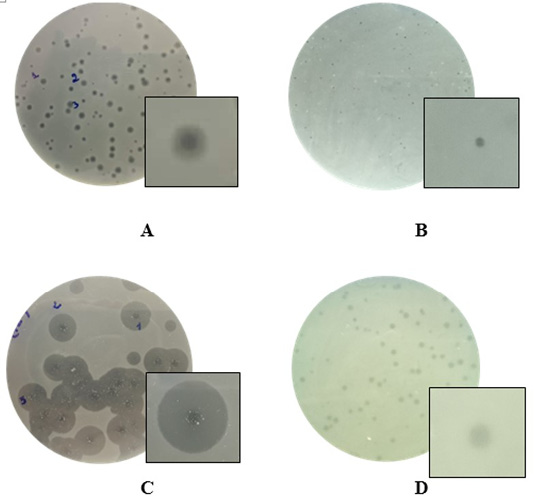

Advances in Animal and Veterinary Sciences
Research Article
Adv. Anim. Vet. Sci. 8(2): 161-166
Figure 1
Examples of diversity of phage plaque morphology following morphological types of plaques are shown: plaques with a halo (A); small-sized pin-headed, clear plaque (B); plaques with clear centers and turbid edges (C), and turbid plaque (D).
Figure 2
Images of phage virions from the Myoviridae family (A – phage MHH6, B – phage PR2).